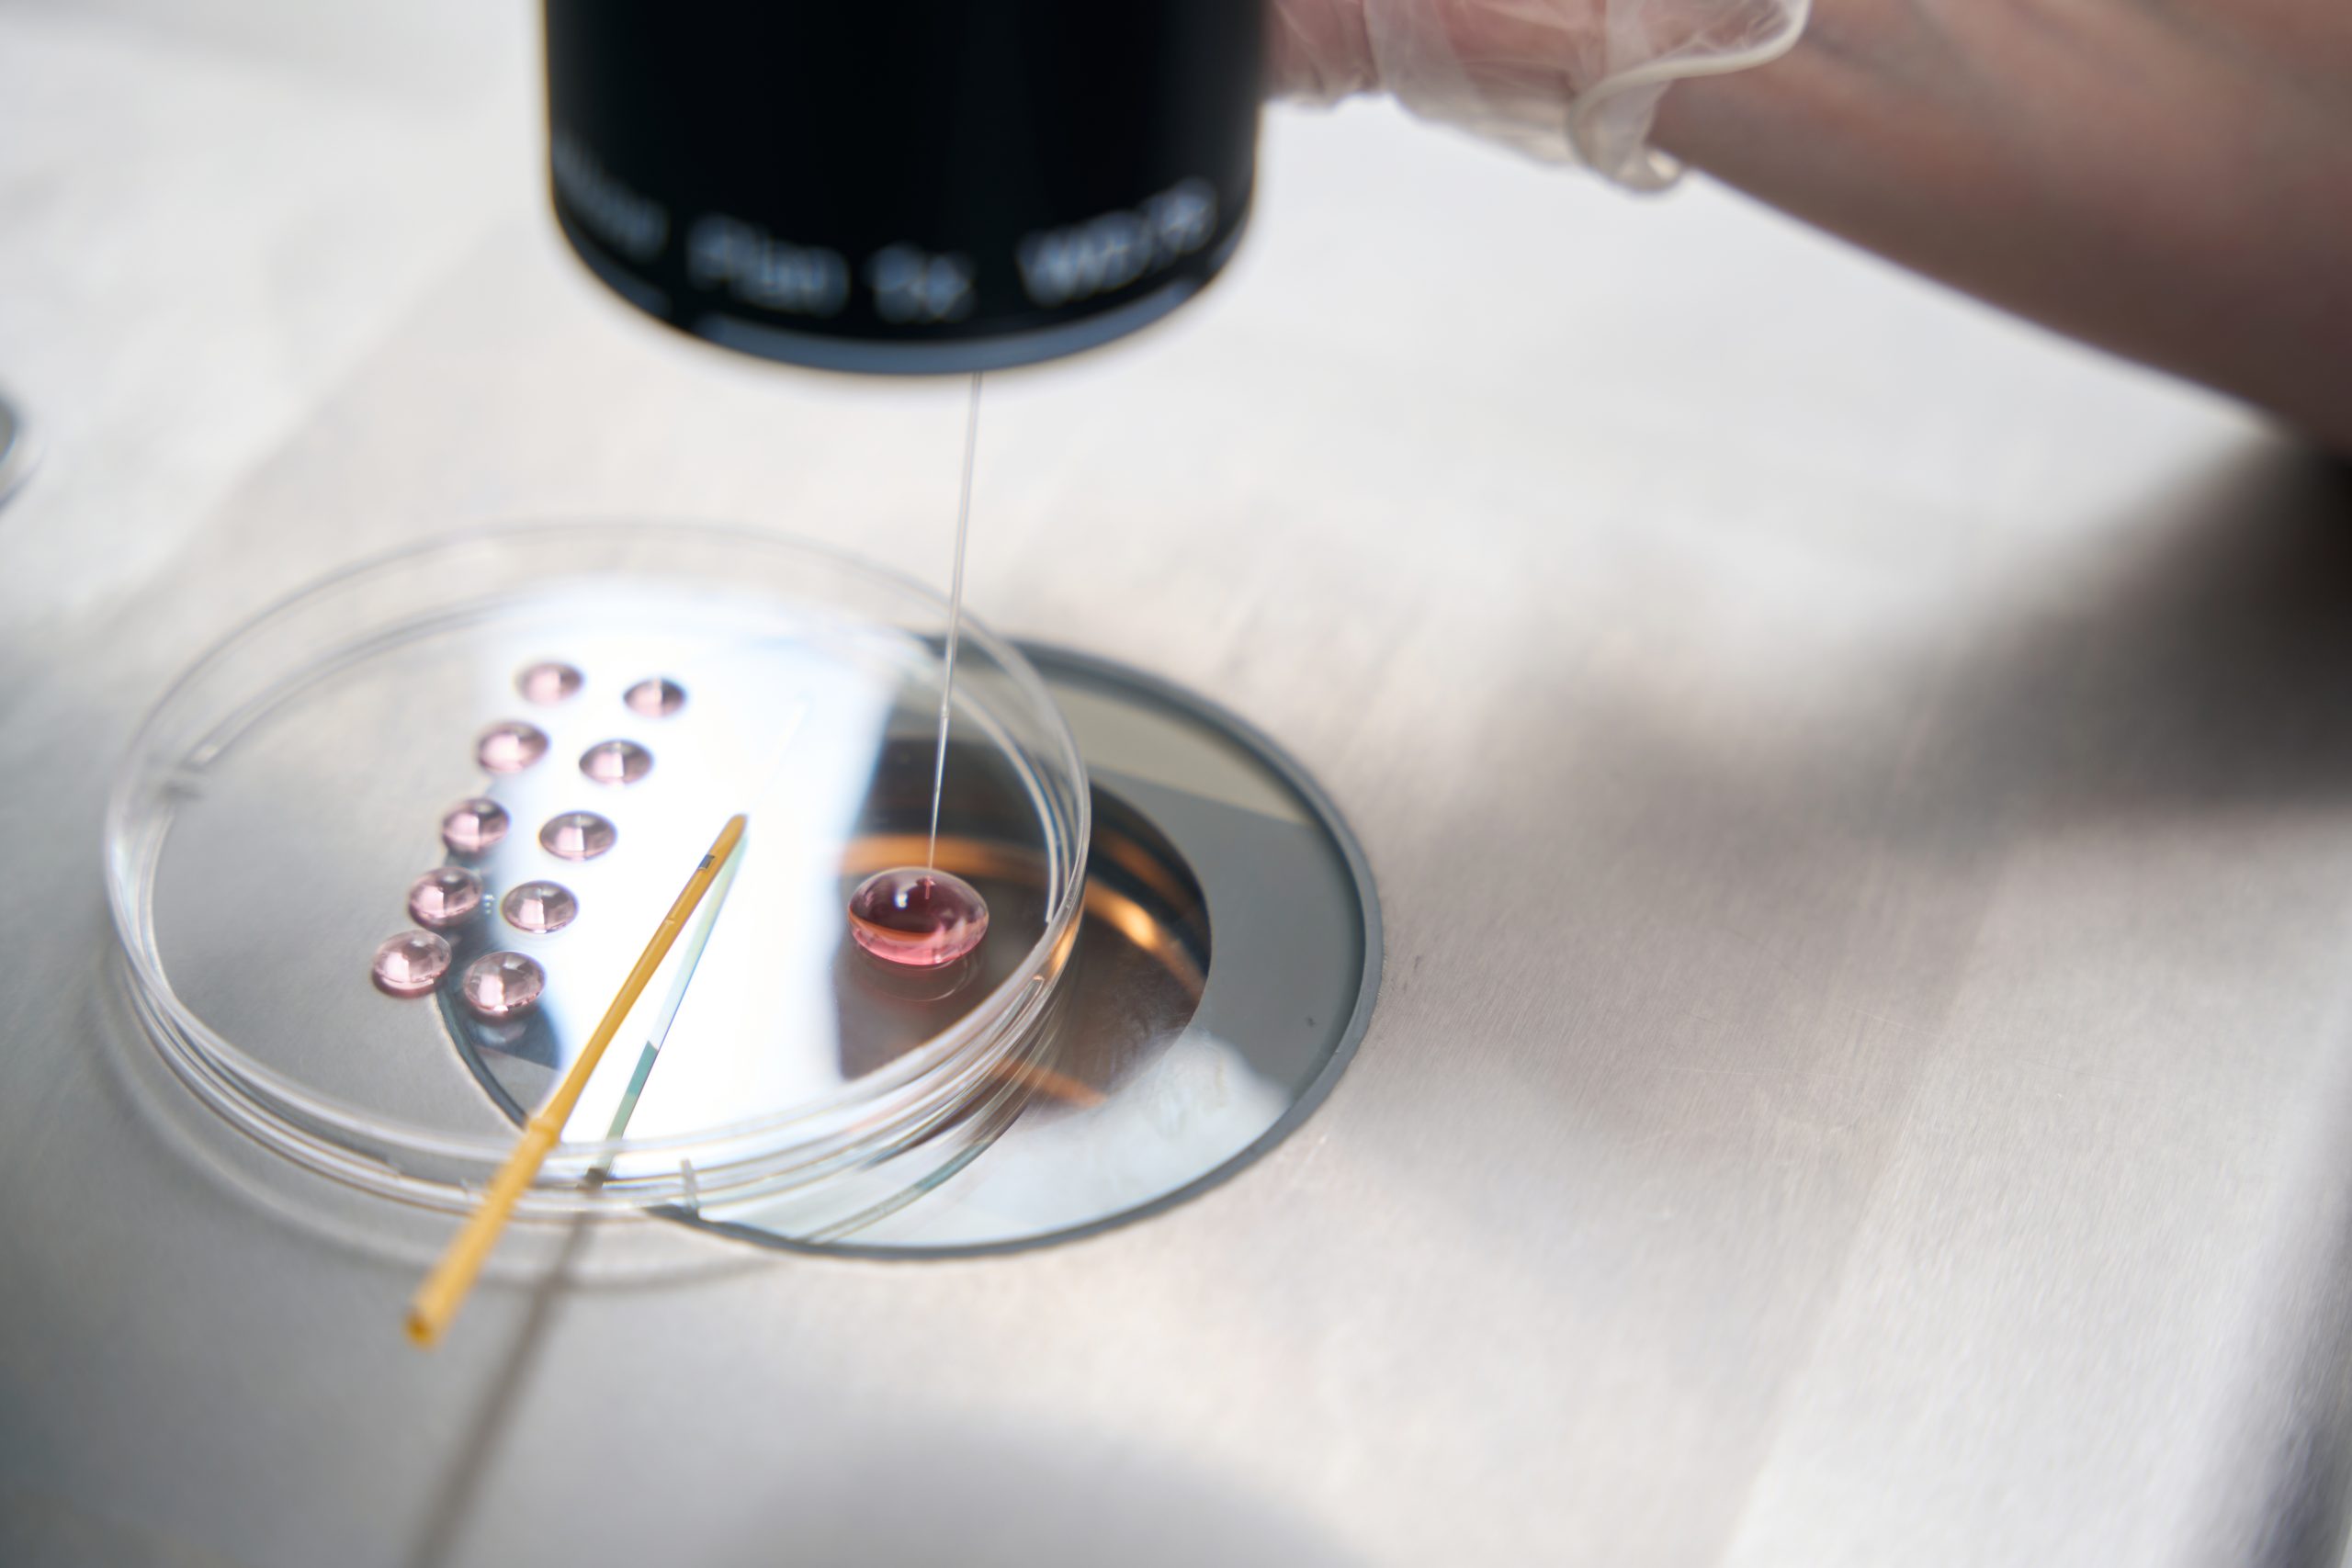
Image

- ERA Test
- Embriyoskop
- Hovuz Usuli
- Gisteroskopiya
- NGS – keng qamrovli xromosoma tekshiruvi
- IMSI
- KKT – Keng qamrovli xromosoma tekshiruvi
- Mikro TESE
- MitoScore / Mitoskor testi nima?
- Microchip
- Mikroxirurgiya bilan sperma aspiratsiyasi (MESA)
- sORP Test
- Bachadon dam olish usuli
- Prenatal Testlar
- PGT- yagona gen kasalliklari uchun
- PGT – xromosoma kasalliklari va kasalliklari uchun
- Genetika (Irsiyat)
- Endoskopik Jarrohlik
- Embriologiya Laboratoriyasi
- Ginekologiya
- Бесплодие и ЭКО
PGT – xromosoma kasalliklari va kasalliklari uchun
Xromosoma kasalliklari va bitta gen kasalliklar uchun ikkita alohida PGT tekshiruvi mavjud. Ushbu bo’limda xromosoma kasalliklari uchun PGT jarayoni muhokama qilinadi.
Xromosoma kasalliklari uchun PGT testi nima?
PGT (Preimplantatsiya genetik diagnostikasi), bu laboratoriya sharoitida olingan embrionlarni onaning bachadoniga o’tkazishtan oldin genetik testen o’tkazish jarayoni.
Nima uchun PGT testi qo’llaniladi?
Inson embrionida jami 46 (23 juft) xromosoma mavjud bo’lib, ularning yarmi onadan, yarmi otadan keladi. Ona nomzodning yoshi, tizimli xromosoma buzilishi (translokatsiya va boshqalar) juftlardan birida bo’lish va boshqa ba’zi biologik va ekologik sabablarga qarab, embrionlarda sonli yoki tarkibiy buzilish xavfi ortishi mumkin.
Ko’pgina xromosoma anomaliyalari hayotga mos kelmaydi, ya’ni ba’zilari (trisomiya 13, 16,18,21,22; monosomiya X)ular embrion bosqichida yoki bachadonga yopishmasdan rivojlanishni to’xtatish yoki bachadonga yopishkan embriyonlar omadsizlik bilan tugaydi, kichik bir qismini (microdeletion sindromi, X [tyorner sindromi monosomy] va trisomiya 21 [down sindrom]) dunyoga keladi va ba’zi aqli zaiflik turli darajadagi birinchi o’rinda turadigan ba’zi kasalliklarga sabab bo’ladi. PGT testining maqsadi-yuqorida aytib o’tilgan xavf guruhlarida normal embrionlarni aniqlash va o’tkazishdan so’ng, homiladorlik tushish xavfini kamaytirish va EKU muvaffaqiyatini oshirishdir.
PGT testi kimga qo’llaniladi?
Dunyo va mamlakatimizda IVF kasallari orasida tobora ko’proq qo’llaniladigan ushbu test, birinchi navbatda, xromosoma anomaliyalari bo’lgan embrionlarni rivojlantirish xavfi yuqori bo’lgan juftliklarda qo’llanilishi tavsiya etiladi.
Xromosoma kasalliklariga PGT yondashuvi, masalan;
- Yoshi katta ayollar,
- Takroriy homiladorlik yo’qotishlar
- Bir necha bor muvaffaqiyatsiz bo’lgan EKU mavjudligi,
- Ota-onalar nomzodida genetik kasallik tashuvchilar (translokatsiya, inversiya va boshqalar.)
- Og’ir erkak bepushtlik,
- Xromosoma anomaliyasi bo’lgan homiladorlik kechirgan juftliklarda tavsiya etilgan usul.
PGT testi qanday amalga oshiriladi?
PGT testi embrion rivojlanishining 3 yoki 5-kunida biopsiya tomonidan olingan hujayralar da amalga oshiriladi. Bugungi kunda ishlatiladigan muzlatish texnikasi va yetishtirish usullarining rivojlanishi bilan hozirgi kunda asosan blastotsist fazasiga (5. kuni yoki 6 kun) embrionlarda qo’llaniladi, vitrinifikatsiya usullari bilan muzlatilgandan so’ng, PGT testi natijasiga ko’ra keyingi muolajada o’tkazish amalga oshiriladi.
Tajribali embriolog tomonidan amalga oshiriladigan va tegishli sharoitlar mavjud bo’lganda embrionning muzlash jarayoni embrionlarning rivojlanish yoki homiladorlikni shakllantirish imkoniyatini kamaytirmaydi; aksincha, ko’pgina ilmiy tadqiqotlar shuni ko’rsatdiki, embrionlar muzlatilib bachadon dam olganda keyin o’tkazilganda, yangi o’tkazilgan muolajalarga nisbatan muvaffaqiyat qozonish ehtimoli ortadi.
PGT testida qaysi usullar qo’llaniladi?
Bizning markazlarimiz; dunyoda eng yangi texnologiya bo’lgan NGS (Next Generation Sequencing) texnikasi qo’llaniladi. Ushbu usul yordamida qisqa vaqt ichida barcha mavjud xromosomalar, mozaika va xromosoma qismlarining nomutanosibligi tekshirilishi mumkin.
PGT testi narxi qanday?
Qonunda talab qilinganidek, PGT testi narxi haqidagi ma’lumotni veb-saytimizda e’lon qila olmaymiz. PGT testi haqida batafsil ma’lumot olish va shifokorlarimiz bilan bepul konsultasya uchun biz bilan bog’lanish formasini to’ldirishingiz mumkin yoki Toshkent : +998 55 512 22 21 , Samarqand : +998 95 061 61 61 , Urganch: +998 90 826 22 24 raqamlardan biz bilan bog’lanishingiz mumkin.
